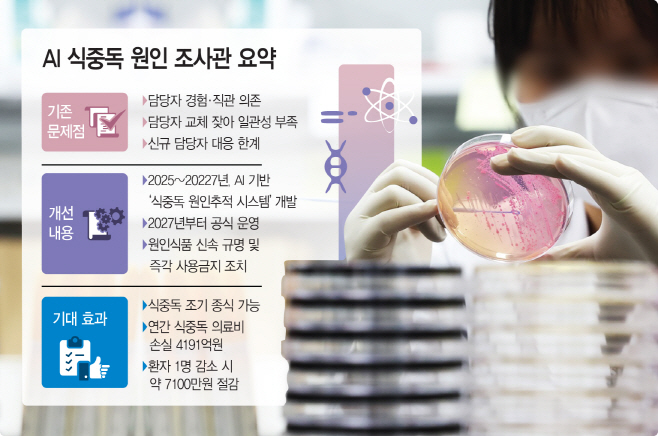
basic_2024

식중독 위험…예측 기반 관리체계로
영세업체까지 식품 안전망 편입
|
|
19일 정부 등에 따르면 식약처는 'AI 식중독 원인추적 시스템'을 본격 추진 중이다. 지금까지 식중독 조사는 각 지방청·지자체 담당자가 식단, 증상, 보존식 등을 수거해 분석하는 방식으로 진행돼 왔지만 앞으로는 AI를 활용해 식중독 원천차단에 앞장서겠다는 것이다.
이는 지구 온난화로 위해 요인이 복잡해지면서 기존의 방식으로는 신속 대응에 한계를 느꼈기 때문이다. 김성곤 식품안전정책국장은 "(식중독) 검사 결과가 나오기 전까지는 사실상 추정에 의존할 수밖에 없어 초동 대응이 늦어지는 구조였다"며 AI조사관의 필요성을 설명했다.
AI 식중독 원인추적 시스템을 통해 당시의 기온·습도 같은 기후 정보, 과거 식중독 데이터베이스(DB)까지 결합, 분석해 가능성이 높은 원인균과 식품을 즉시 제시하는 방식으로 접근한다. 기후 변화로 인해 곰팡이독소, 패류독소, 병원성 미생물 등 위해요소가 증가하는 상황에서, '식품 위해예측 시스템'을 구축해 환경 데이터와 위해요소 데이터를 결합 분석하는 체계를 만든다는 것이다. 이는 식중독이 발생한 뒤 대응하던 기존 구조에서 벗어나, 발생 가능성을 사전에 감지·차단하는 첫 시스템이다.
식약처는 올해 개발을 시작해, 2027년까지 시범 운영을 거쳐 전국에 확대한다는 계획이다. 그동안 담당자 교체가 잦고 신규 조사관의 경험 부족으로 일관된 대응이 어려웠던 문제는 AI로 균형을 맞출 예정이다. 김 국장은 "식중독 업무는 강도가 높고 담당자 교체가 잦아 조사 편차가 크다"며 "AI가 최소한의 기준점 역할을 해줄 것"이라고 말했다.
뿐만 아니라 AI 조사관 도입을 통해 경제적 효과도 상당할 것이라는 평가가 나온다. 식약처에 따르면 2022년 기준 식중독 의료비 손실만 연 4191억원에 달하며, 사회·경제적 총 손실은 1조8746억원으로 추산된다. 상황이 이렇다 보니 일각에선 식중독으로 개인에게 돌아가는 부담이 1215억원(전체의 89%)에 달한다며, 정부의 예방 투자 확대가 필수적이라는 지적도 나온다.
이에 따라 정부는 내년도 먹거리 안전·영양 환경 조성 예산을 1871억원으로 편성했다. 농축수산물 안전관리 예산은 52억원에서 78억원으로, 온라인 식의약 안전관리(30억원), 위생용품 안전관리(16억원) 등 식중독 발생 요인을 다층적으로 관리하는 항목을 강화했다. 아울러 영세업체의 스마트 HACCP 도입을 위해 센서 구축 비용을 지원하는 등 민간 안전관리 수준을 끌어올리는 정책도 함께 추진된다.
식약처 관계자는 "사전예측, 현장조사, 조기 차단으로 이어지는 첨단 대응 체계를 구축해 국민이 체감하는 먹거리 안전 시대를 열겠다"고 강조했다.